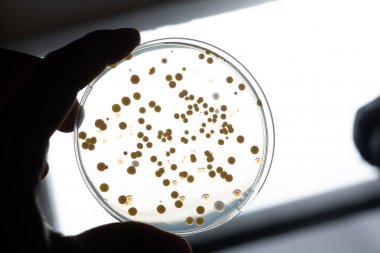

生化試劑盒 - 超氧化物歧化酶(SOD)活性檢測試劑盒說明書
Superoxide Dismutase (SOD) Activity Assay Kit
一、超氧化物歧化酶(SOD)活性檢測試劑盒產品描述
超氧化物歧化酶(SOD)是一種廣泛存在于生物體內的金屬酶,作為重要的氧自由基清除劑,能 催化超氧化物陰離子發生岐化作用,生成 H2O2 和 O2。SOD 不僅是超氧化物陰離子清除酶,也是 H2O2 主要生成酶,在生物抗氧化系統中具有重要作用。 黃嘌呤及黃嘌呤氧化酶反應系統能夠產生超氧陰離子(O2 -),O2 -可還原氮藍四唑生成藍色甲臜, 產物在 560 nm 處具有特征吸收峰;SOD 可清除 O2 -,從而抑制了甲臜的形成,反應液顏色越深,表 明 SOD 活性愈低,反之活性越高,通過吸光值的變化即可表征 SOD 的活性。

二、超氧化物歧化酶(SOD)活性檢測試劑盒產品內容圖示

三、超氧化物歧化酶(SOD)活性檢測試劑盒產品使用說明
測定過程中所需要的儀器和試劑:可見分光光度計/酶標儀、微量玻璃比色皿(光徑 10 mm)/96 孔板、研缽/勻漿器、可調式移液器、臺式離心機、恒溫水浴/培養箱和蒸餾水。
①粗酶液的制備(可根據預實驗結果適當調整樣本量及比例) ①組織:按照組織質量(g):提取液體積(mL)為 1:(5-10)的比例(建議稱取 0.1 g 組織,加 入 1 mL 提取液)處理樣品,冰浴勻漿,4℃ 8000 g 離心 10 min,取上清置于冰上待測。
②細菌或細胞:離心收集細菌或細胞至離心管內,按照細菌或細胞數量(104 個):提取液體積(mL) 為(500-1000):1 的比例(建議 500 萬個細菌或細胞加入 1 mL 提取液)處理樣品,冰浴超聲破碎(功 率 20%或 200 W,超聲 3 s,間隔 10 s,重復 30 次),4℃ 8000 g 離心 10 min,取上清置于冰上待測。
③血清(漿)、培養液等液體樣本:直接檢測或使用提取液適當稀釋后再進行檢測。

吸光值測定:測定 560 nm 處吸光值,記為 A 測定、A 對照、A 空 1、A 空 2;計算 ΔA 測定=A 測定-A 對照,ΔA 空白=A 空 1-A 空 2。注:空白管 1 和空白管 2 只需測定 1-2 管,每個樣本均需設一 個對照管。
超氧化物歧化酶(SOD)活性計算 (1)抑制百分率的計算

注:抑制百分率應控制在 30-70%范圍內,越靠近 50%越準確;若抑制百分率小于 30%或大于 70%, 則需要調整樣本量后重新測定:若抑制百分率偏高,則需適當稀釋樣品;若抑制百分率偏低,則需適 當增加樣本量后再進行測定,計算時相應修改
SOD 酶活性計算公式圖示:

注釋:V 反總:反應體系總體積,0.2 mL;V 樣:反應體系中加入粗酶液的體積,0.02 mL;V 樣 總:粗酶液總體積,1 mL;Cpr:粗酶液蛋白濃度,mg/mL;W:樣品質量,g;500:細胞或細菌總 數,500 萬;D:樣本稀釋倍數。
四、超氧化物歧化酶(SOD)活性檢測試劑盒注意事項
①待測樣本和試劑二使用時在冰上放置;
②樣本較多時可按表格中試劑用量配置工作液(包含試劑一、二、三),試劑五必須最后加入;
③為保證結果準確且避免試劑損失,測定前請仔細閱讀說明書(以實際收到說明書內容為準), 確認試劑儲存和準備是否充分,操作步驟是否清楚,且務必取2-3個預期差異較大的樣本進行預測定, 過程中問題請您及時與工作人員聯系。
